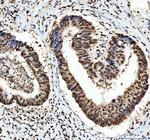
hnRNP L Antibody in Immunohistochemistry (Paraffin) (IHC (P))

Search
Invitrogen
hnRNP L Polyclonal Antibody
{{$productOrderCtrl.translations['antibody.pdp.commerceCard.promotion.promotions']}}
{{$productOrderCtrl.translations['antibody.pdp.commerceCard.promotion.viewpromo']}}
{{$productOrderCtrl.translations['antibody.pdp.commerceCard.promotion.promocode']}}: {{promo.promoCode}} {{promo.promoTitle}} {{promo.promoDescription}}. {{$productOrderCtrl.translations['antibody.pdp.commerceCard.promotion.learnmore']}}
图: 1 / 12
hnRNP L Antibody (PA5-79383) in ICC/IF

Please note: We are reviewing Western blot images included in the antibody testing data in our catalog, including those provided by third parties. Unless expressly labeled or annotated as “raw-unedited”, Western blot images included in the antibody testing data in our catalog may have been edited, optimized or otherwise adjusted for presentation.
产品信息
PA5-79383
种属反应
宿主/亚型
分类
类型
抗原
偶联物
形式
浓度
规格
纯化类型
保存液
内含物
保存条件
运输条件
RRID
产品详细信息
Reconstitute with 0.2 mL of distilled water to yield a concentration of 500 µg/mL.
Positive Control - WB: human Jurkat whole cell, human MCF-7 whole cell, human PC-3 whole cell, human U87 whole cell, rat liver tissue, mouse liver tissue, mouse RAW2647 whole cell, mouse NIH/3T3 whole cell. IHC: human breast cancer tissue, human colorectal adenocarcinoma tissue, human laryngeal squamous cell carcinoma tissue, human liver cancer tissue, human lung adenocarcinoma tissue, mouse liver tissue, rat liver tissue. ICC/IF: MCF-7 cell.
靶标信息
Heterogeneous nuclear RNAs (hnRNAs) which include mRNA precursors and mature mRNAs are associated with specific proteins to form heterogenous ribonucleoprotein (hnRNP) complexes. Heterogeneous nuclear ribonucleoprotein L is among the proteins that are stably associated with hnRNP complexes and along with other hnRNP proteins is likely to play a major role in the formation, packaging, processing, and function of mRNA. Heterogeneous nuclear ribonucleoprotein L is present in the nucleoplasm as part of the HNRP complex. HNRP proteins have also been identified outside of the nucleoplasm. Exchange of hnRNP for mRNA-binding proteins accompanies transport of mRNA from the nucleus to the cytoplasm. Since HNRP proteins have been shown to shuttle between the nucleus and the cytoplasm, it is possible that they also have cytoplasmic functions. Two transcript variants encoding different isoforms have been found for this gene.
仅用于科研。不用于诊断过程。未经明确授权不得转售。
篇参考文献 (0)
生物信息学
蛋白别名: FLJ35509; Heterogeneous nuclear ribonucleoprotein L; heterogenous nuclear ribonucleoprotein L; hnRNP L
基因别名: C79783; D830027H13Rik; Fblim1; hnrnp-L; HNRNPL; HNRPL; P/OKcl.14
UniProt ID: (Mouse) Q8R081, (Rat) F1LQ48
Entrez Gene ID: (Mouse) 15388, (Rat) 80846




